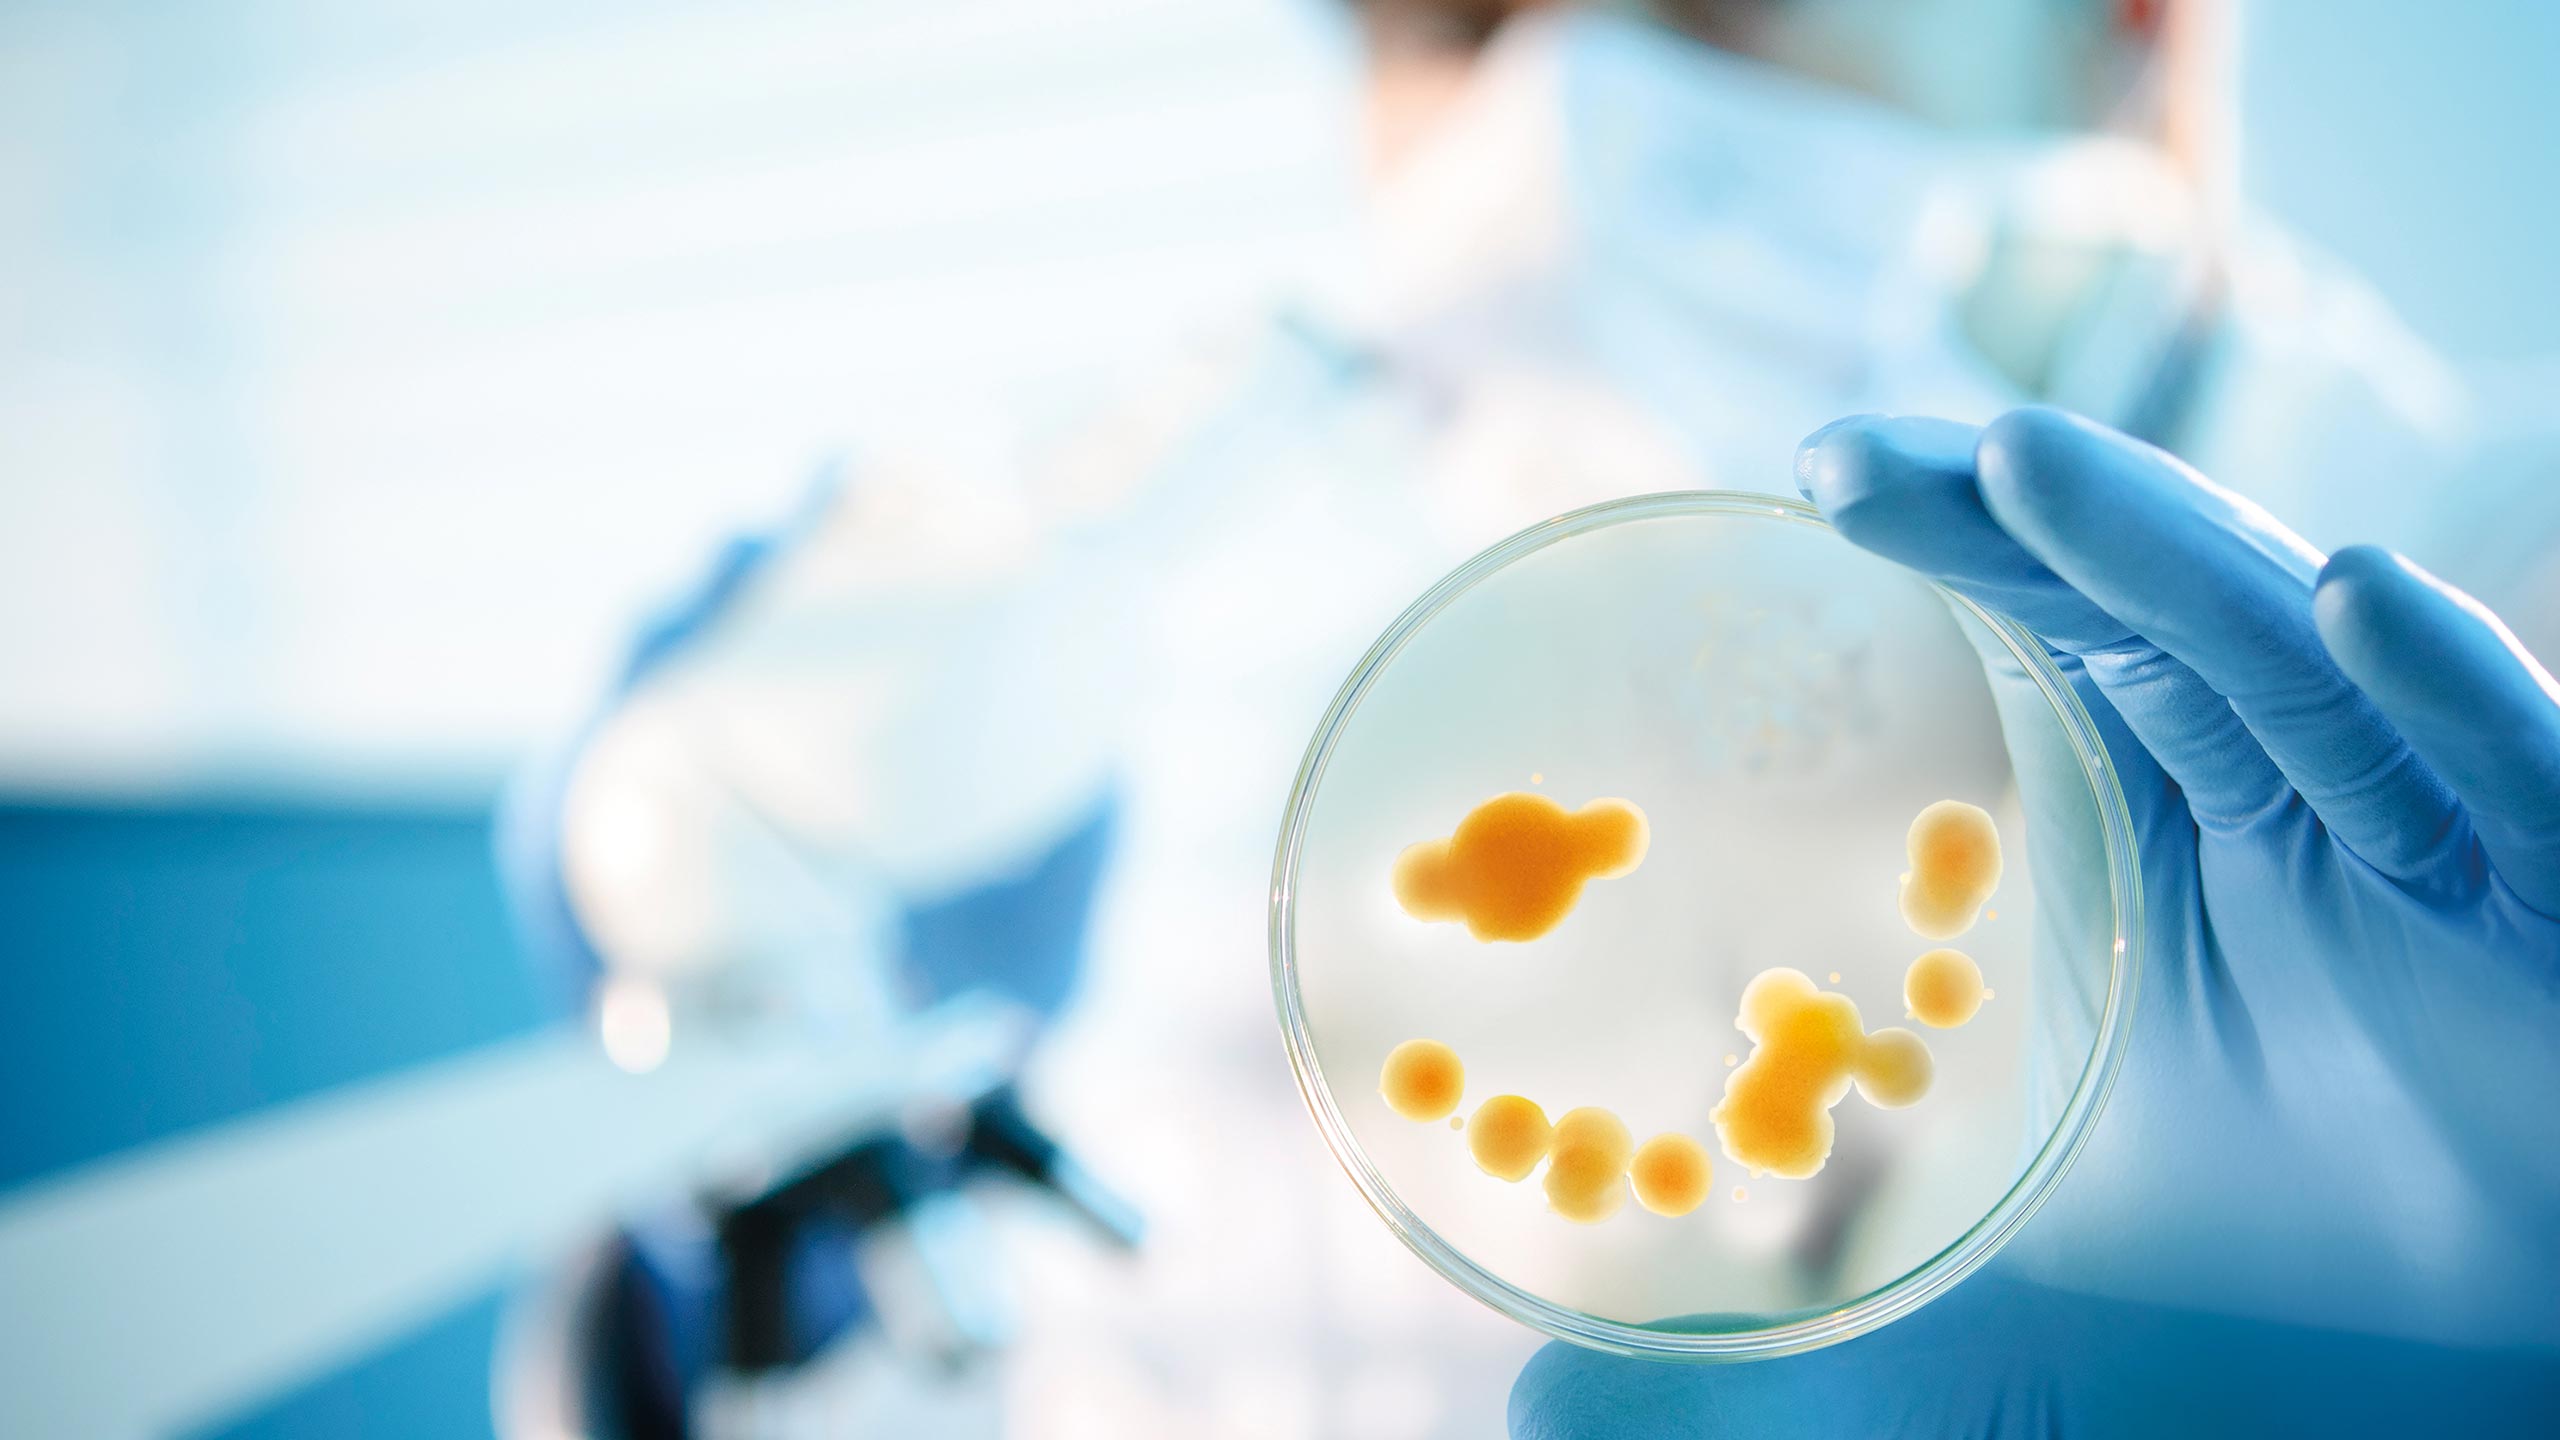
Link zu Wissenschaft Link zu Wissenschaft

GASES FOR LIFE
Was sind „Gases for Life“? Wir bezeichnen damit Gase, die in der Industrie, im Umweltschutz, in der Medizin, der Lebensmittelbranche, der Schweiß- und Schneidtechnik, im 3D-Druck, im Bauwesen sowie in der Forschung und Wissenschaft eingesetzt werden. Oder anders gesagt: Gase spielen in fast allen Bereichen unseres täglichen Lebens eine unsichtbare, aber sehr wichtige Rolle. Viele dieser Gase gewinnen wir direkt aus der Umgebungsluft.
Lust, die Vielfalt von „Gases for Life“ zu entdecken und mehr über ihre faszinierenden Einsatzmöglichkeiten zu erfahren? Los geht’s!
GASE SIND ÜBERALL
Ganz alltägliche Dinge, die wir täglich nutzen oder genießen, haben ein unsichtbares „Erfolgsgeheimnis“: Industriegase. Entdecken Sie hier, was dahinter steckt.